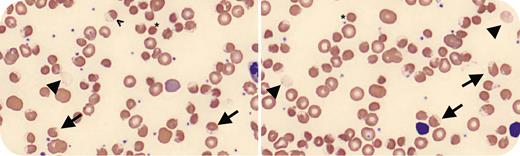
graphic

A 32-month-old boy presented with jaundice and dark urine. He had decreased pulse-oximetry measurements of 77% with no improvement despite continuous positive pressure ventilation with 100% fraction of inspired oxygen (FiO2). Laboratory results were notable for hemoglobin 5.3 g/dL with reticulocyte count 6.2%, total bilirubin 3.7 mg/dL, lactate dehydrogenase 1581 U/L, and haptoglobin <20.0 mg/dL. Methemoglobin was elevated at 6.3%. Urinalysis was consistent with hemoglobinuria. Peripheral blood smear examination (original magnification ×100) demonstrated numerous blister and bite cells (arrows) as well as red blood cell ghosts (arrowheads), hemighosts (carets), and spherocytes (asterisks). Given the concern for oxidative hemolysis, further history was obtained, revealing that he had eaten fava beans for the first time 2 days prior to presentation. A glucose-6-phosphate dehydrogenase (G6PD) deficiency screen was positive, which reflexed to a quantitatively low level of 3.1 U/g hemoglobin. He received a total of 20 mL/kg of transfused packed red blood cells, and his parents received counseling about future avoidance of certain medications, fava beans, and other exposures such as naphthalene moth balls.
Methemoglobinemia is sometimes seen in favism, which can result in decreased pulse-oximetry measurements despite oxygen supplementation. Treatment includes transfusion support. Therapeutic IV vitamin C has been reported because methylene blue is contraindicated in G6PD deficiency.
For additional images, visit the ASH Image Bank, a reference and teaching tool that is continually updated with new atlas and case study images. For more information, visit https://imagebank.hematology.org.